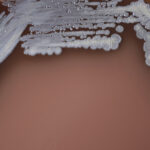
nu am mai vazut asa ceva o boala tropicala rara aparuta dupa inundatiile din nord estul australiei se raspandeste rapid 67bee0a39fbf4

Marele defect al lui Ianis Hagi, evidențiat de fostul șef al scouterilor de la Manchester United
Ianis Hagi, considerat de unii specialiști drept un jucător de talie mondială, a fost subiectul unor comentarii critice din partea lui Mick Brown, fostul șef al scouterilor de la Manchester United. Într-un interviu recent, Brown a subliniat atât calitățile, cât și defectele internaționalului român, în contextul speculațiilor legate de prelungirea contractului său cu Rangers.
„El (n.r. – Ianis Hagi) poate să facă ceva special, după care dispare din joc și e ca și cum ai juca în zece, cu un om în minus“, a declarat Brown, evidențiind stilul de joc al lui Hagi, care depinde de alți jucători pentru a primi mingea. Această abordare îl face vulnerabil pe teren, iar echipa poate fi expusă.
Brown a continuat să discute despre importanța stabilirii rolului lui Hagi în echipă, având în vedere și situația financiară a clubului. „Treaba aceasta trebuie pusă în balanță în această discuție. Să pierzi un jucător de bază, când ai probleme financiare, e o mare lovitură“, a adăugat el, subliniind că decizia privind viitorul lui Hagi este în curs de analiză.
Marele defect al lui Ianis Hagi
Fostul șef al scouterilor de la Manchester United, Mick Brown, a evidențiat un aspect important în evoluția lui Ianis Hagi. Potrivit acestuia, Hagi are momente de strălucire în joc, dar suferă de un defect care îi limitează performanța constantă. Brown a subliniat că, deși Hagi poate „face ceva special”, există o lipsă de continuitate în prestațiile sale, ceea ce poate afecta șansele sale de a rămâne într-un club de top.
Acesta a adăugat că, în contextul actual, cluburile ar trebui să facă tot posibilul pentru a-l păstra pe Hagi, mai ales în condițiile în care pierderea unor jucători valoroși fără compensație financiară nu este o opțiune viabilă.